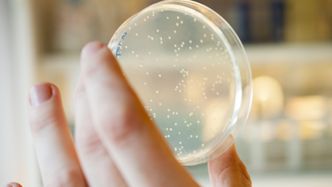
Her ser vi kolonier av bakterien E. coli, som brukes til produksjon av mange terapeutiske proteiner. Foto: Håvard Egge

Det lille biotekselskapet Vectron Biosolutions med utspring fra NTNU har utviklet ny produksjonsteknologi for proteiner til terapeutisk bruk. Nå begynner farmasiindustrien å ta teknologien i bruk.
– Fordelen med vår metode er økt produksjonsutbytte og kvalitet på proteinene, forteller gründer i Vectron Biosolutions, Trond Erik Vee Aune.
Å produsere proteiner til terapeutisk bruk er utfordrende. De er nemlig så komplekse at de er umulige å lage med vanlige kjemiske metoder.
– Et protein kan bestå av tusenvis av atomer satt sammen på en helt bestemt måte. Små endringer i plasseringen til disse atomene kan føre til at proteinene ikke virker, eller i verste fall gir sterke bivirkninger, forklarer Aune.
Insulin fra griser
For å produsere proteiner for terapeutisk bruk måtte man helt frem til 1980-tallet isolere mange proteiner fra de organismene der de naturlig lages.
Et eksempel på dette er insulin som man før utvant fra grisekadavre. Det ble naturligvis et paradigmeskifte i industrien da dagens metode, den rekombinante DNA-teknologien, ble utviklet.
– Denne teknologien går ut på å genmanipulere en bakteriecelle eller annen levende celle til å produsere proteinene for oss. Dette gjøres ved å sette inn et minikromosom som inneholder det genet som har oppskriften på proteinet man ønsker å produsere. Metoden er utrolig nøyaktig og effektiv fordi den gjør de levende cellene i stand til å bygge proteiner, forteller Aune.


Bedre kvalitet
Vectrons videreutvikling av teknologien er egne minikromosomer og produksjonsmetoder, som fører til at bakteriecellen produserer større mengder av det ønskede proteinet, med høyere kvalitet.
– Hvor mye vi klarer å produsere varierer fra protein til protein, men for noen typer er utbyttet det mangedobbelte av hva man får med
konkurrerende teknologier, forteller Aune.
I tillegg unngår man et tidkrevende og dyrt steg i produksjonen.
– Dette gjør at proteinene kan produseres betydelig rimeligere enn med andre metoder, uten at det fører til noen forskjell på selve sluttproduktet.
Aune tror Vectrons teknologi vil komme pasientene til gode.
– Dyre medisiner er et stort globalt helseproblem. Til og med i rike Norge er enkelte proteinbaserte medisiner utilgjengelig for deres pasientgrupper fordi de er for dyre i innkjøp. Med vår teknologi vil medisinprodusentene kunne kutte prisene uten å tape profitt.
Avhengig av markedet
Aune håper at lavere produksjonskostnader også vil føre til at medisinprodusentene tar seg råd til å utvikle medisin de tidligere ikke hadde mulighet til.
.png)

– Å utvikle en ny medisin koster mer enn
15 milliarder kroner i gjennomsnitt. Dette har ført til at farmasøytiske selskaper ikke lager medisin til sykdommer der markedet er for lite til å få dekket utviklingsutgiftene, forteller Aune.
Trond Erik Vee Aune startet det lille biotekselskapet i 2008 sammen med professor i bioteknologi ved NTNU, Svein Valla. Sistnevnte har ledet forskningen på den nye teknologien.
For noen år siden ville industrien antakelig ikke vært interessert i ny teknologi, tror Aune, men situasjonen har forandret seg ettersom patentene til mange terapeutiske proteiner nå har begynt å gå ut. Dette har ført til at det har begynt å dukke opp selskaper som lager kopimedisiner, og monopolsituasjonen i industrien opphører.
– Før var ikke insentivene sterke nok til å bruke ny teknologi, men nå er selskaper med innovative og kostnadsbesparende løsninger blitt svært attraktive, utdyper han.
Syv år før første avtale
Det tok Vectron hele syv år å få den første avtalen underskrevet. Bak ligger det langvarig nettverksbygging, relasjonsbygging og mange
forsøksresultater som svarer på en del spørsmål de ulike selskapene har hatt, ifølge Aune.
– Det har vært intenst og målrettet arbeid hele veien. Det er så lang tid det tar, mener han, og forteller at de fikk mange klapp på skuldrene etter å ha landet avtalen.
– Folk sa til oss at de har brukt ti år på å lande lignende samarbeid, selv om de allerede var etablert. Dette er en konservativ industri, som er ekstremt redd for å ta i bruk ny teknologi, for om noe går galt kan de tape hundrevis av
millioner kroner.
Strategisk avtale
I fjor inngikk Vectron en stor lisensavtale med det tyske selskapet Boehringer Ingelheim. Avtalen kan bli verdt fra 100 til 500 millioner kroner i løpet av ti til tyve år.
– Lisensavtalen er verdifull for oss i form av inntektene vi vil få, men det aller viktigste er at avtalen fungerer som en validering av vår teknologi fra en av bransjens mest konservative selskaper.
Avtalen har ført til at bransjen føler seg trygg på Vectrons teknologi, og har allerede åpnet opp for flere muligheter.
– For tiden er vi i dialog med tre store farmasiselskaper som ønsker hjelp til produksjon av en type protein som omsettes for omtrent 200 milliarder i året, forteller Aune.
Vectron starter utviklingsprosjekter med disse selskapene i år og håper å ha nye avtaler på plass innen utgangen av 2018.
Inspirerer
Legemiddelindustrien (LMI) synes det er veldig bra at Vectron bygger opp kompetanse på dette feltet, og at de klarer å få avtaler med store legemiddelselskaper.
– Slike samarbeid mellom små norske og store globale selskaper bidrar til hele næringen og inspirerer forskerne. Hvor viktig metoden er, og hvor kostnadseffektiv den blir, må hver produsent finne ut av for sine egne produkter. Hvis det blir noen billigere produkter ut av dette er det kjempebra, sier seniorrådgiver Eckart Holtz i LMI.





